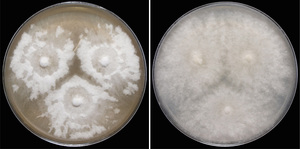

“The Cuban Scientist” (or TCS for short) is a free and open access online journal where scientists from all branches of science and technology can share their research results with the community in the form of two-page reports, summarizing works already published in peer-reviewed journals.
Our mission
TCS’s mission is to establish and strengthen ties among Cuban scientists by contributing to their self-awareness as a community, fostering collaboration and facilitating knowledge-sharing. It aims to serve as a free information layer bypassing geographical and institutional barriers. Our goal is that TCS one day becomes the reference point for ‘science made by Cubans’.
Who can publish?
We interpret ‘Cuban’ in an inclusive way, i.e. comprising all scientists who identify themselves with this community, regardless of their place of birth or where they live.
En Español
Para leer en español un resumen de los objetivos de la revista y las pautas de publicación descargue este documento PDF.
Latest reports
Cuban Sci. 2025, 6(1): 3–4Gregorio Delgado, Jose G. Maciá-Vicente
9 Nov 2025 PDF (515K)“Three novel fungal species belonging to the diatripaceous genus Monosporascus: M. bulgaricus, M. europaeus and M. solitarius, were described as new root-endophytic fungi from Europe.”
Cuban Sci. 2025, 6(1): 1–2Gregorio Delgado
3 Aug 2025 PDF (4.16M)“Three novel genera and six species of asexual Ascomycota were described as new from south Florida. Additionally, thirty-two other microfungi were newly recorded from the United States.”

Cuban Sci. 2024, 5(1): 7–8Federico Abraham Ceruti, Maybı́ Morell-Ruiz
8 Jul 2025 PDF (327K)“A pilot study with eight children (ages 6–8) explored their use of visual probabilistic information in a task
where Lucy lemur plays the roulette. Children estimated happiness of Lucy and chose games based on probabilities, showing consistent choices matching the two modalities and no clear preference for specific probability
values. Results indicate that young children can process complex visual probabilistic information and make
consistent estimates, laying the groundwork for further research on probabilistic reasoning.”

Cuban Sci. 2024, 5(1): 5–6Filonov Valery Ruslanovich
20 May 2025 PDF (117K)“The philosophical understanding of media space involves complexity in its systematization and theorization. This article explores the perception, interaction, and impact of media space on social reality and knowledge.”
Cuban Sci. 2024, 5(1): 3–4Antonio Mijail Pereza, Jose Manuel Zolotoff
20 May 2025 PDF (389K)“This study analyzes bird and bat collisions at a wind power plant in Rivas, Nicaragua, based on eight monitoring campaigns from 2014 to 2022. Results reveal species-specific patterns and seasonal peaks, emphasizing the importance of continuous biodiversity monitoring during key migration and breeding periods.”

Cuban Sci. 2024, 5(1): 1–2Maikel Leon
20 May 2025 PDF (134K)“GenAI-Powered Learning (GAIL) is proposed as a pedagogy to enhance student engagement and productivity. This approach builds on existing methodologies such as Problem-based Learning (PBL), Collaborative Online International Learning (COIL), and the Harkness method (HM). GAIL offers a needed perspective on education that aligns with the current AI-driven technological wave.”